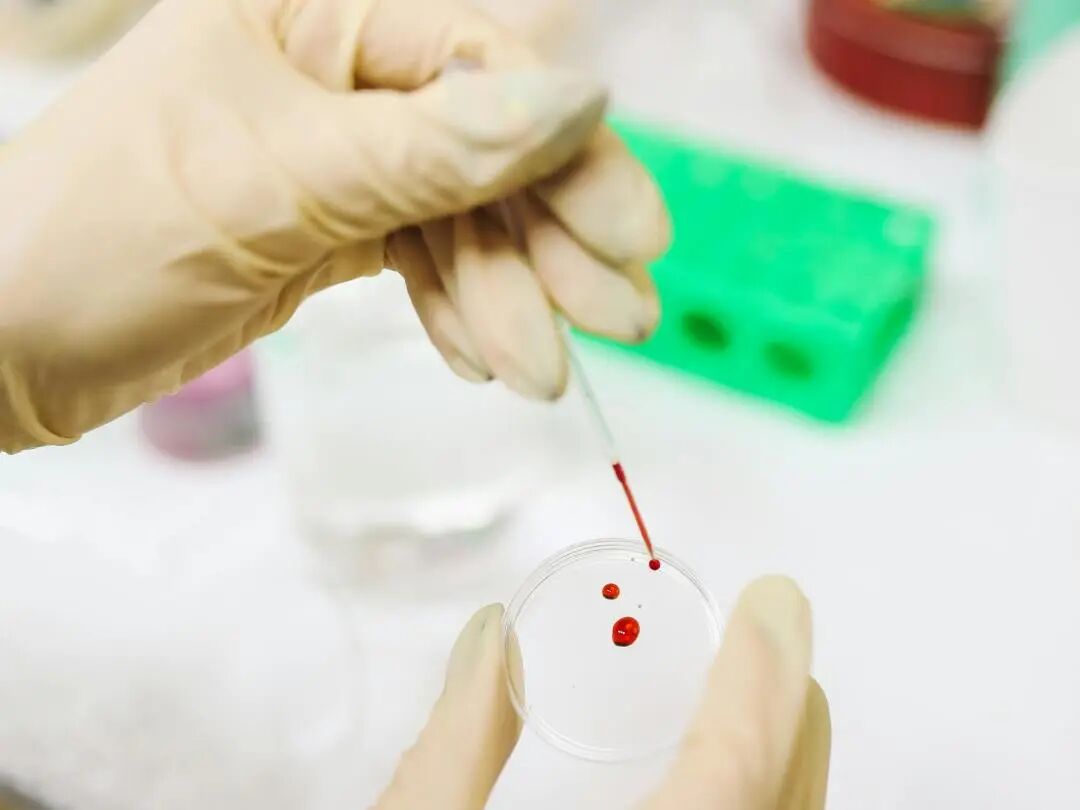

亲子鉴定不去医院,到底可以到哪做?


许多人第一反应是去医院做亲子鉴定,但实际上大部分医院并不提供这项服务,医院不做亲子鉴定主要有三个原因:
1. 不属于常规医疗服务:亲子鉴定本质是"法医物证鉴定",属于司法与基因检测领域,并非医院的诊断治疗范畴。
2. 缺乏必备资质与设备:需要《司法鉴定许可证》和CNAS认证的基因检测实验室,普通医院通常不具备。
3. 无专业鉴定人员:需要持有"司法鉴定人执业证"的专业人员,而非常规医护人员。
图片来源:Pexels
如果鉴定结果是用于上户口、迁户口、打官司、遗产继承、移民签证等需要法律认可的场合,需要到司法鉴定机构进行检测,可通过当地司法局官网查询具有资质的司法鉴定机构名录;如果仅个人了解真相,不需要法律效力的,寻找正规机构即可。
1、司法鉴定机构必须持有《司法鉴定许可证》,且许可证是在有效期内,业务范围包含"法医物证鉴定"。
2、实验室认证需要通过 CNAS(中国合格评定国家认可委员会)认证或CAP(美国病理学家协会)认证(国际认可)。
3、鉴定人员需持有《司法鉴定人执业证》。

图片来源:Pexels
1、预约申请:联系司法鉴定所,准备身份证、户口本等证件;
2.、现场办理:所有被鉴定人携带证件原件到场;
3、身份核验:法医核对证件、拍照、采集指纹;
4、样本采集:现场采集血液样本,全程录像;
5、等待报告:通常5-7个工作日出具司法鉴定意见书。
总而言之,不去医院做亲子鉴定,您可以选择到司法鉴定机构进行检测。检测前一定要严格核查机构资质,确保结果准确、过程保密、权益受保护。
END

暨南大学司法鉴定中心公众号
司法鉴定咨询/预约电话:
18011833065(微信同号)

暨南大学司法鉴定中心服务号
亲子鉴定 指纹鉴定 验伤/评残
死因鉴定 医疗损害 民事行为能力

日期:2026年3月16日 16:07
